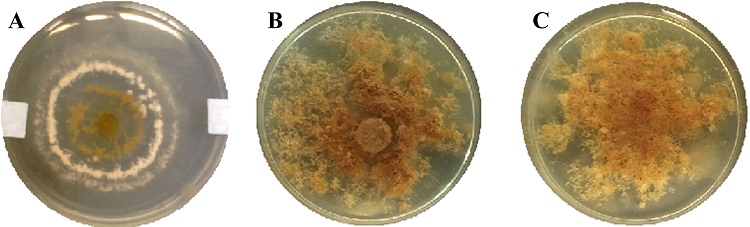
Im&aacute;genes fotogr&aacute;ficas macrosc&oacute;picas del anverso de las cepas f&uacute;ngicas obtenidas luego de 7 d&iacute;as de crecimiento. A) HEP25; B) HEP15; C) HEP28.

Taxonomía y sistemática
Aislamiento y caracterización morfológica y molecular de cepas de Escovopsis aisladas de nidos de hormigas cortadoras de hojas de Argentina
Isolation and morphological and molecular characterization of Escovopsis strains isolated from leaf-cutting ant nests from Argentina
Aislamiento y caracterización morfológica y molecular de cepas de Escovopsis aisladas de nidos de hormigas cortadoras de hojas de Argentina
Revista mexicana de biodiversidad, vol. 91, e912581, 2020
Instituto de Biología
Recepción: 09 Enero 2018
Aprobación: 11 Febrero 2019
Financiamiento
Fuente: Universidad Nacional de Misiones
Nº de contrato: 16Q524
Resumen: Escovopsis es un género descrito recientemente para el cual se han reportado 5 nuevas especies en los últimos 6 años. La identificación de especies fúngicas está basada en la morfología de las estructuras reproductivas. Actualmente, el uso de marcadores genéticos basado en secuencias del ADN ribosomal ha ganado aceptación en numerosas aplicaciones, como la identificación molecular de la diversidad fúngica. El objetivo del presente estudio fue aislar e identificar morfológica y molecularmente cepas de Escovopsis nativas de Argentina. A partir de muestras de suelo y cultivos de hongos de nidos de hormigas cortadoras de hojas se aislaron 3 cepas de Escovopsis. Se realizó la identificación taxonómica y posterior extracción de ADN. Se amplificó la región ITS1-5,8S-ITS2 del ADNr. Este es el primer trabajo que registra el aislamiento e identificación morfológica de cepas del hongo biocontrolador del género Escovopsis nativas de Misiones (Argentina): 2 pertenecientes a la especie E. weberi y una a la especie E. microspora. Particularmente, para la cepa E. microspora, se logró complementar la identificación morfológica con métodos moleculares y análisis filogenéticos. La secuencia nucleotídica obtenida de E. microspora representa una contribución para futuros estudios en el marco del análisis molecular de la región ITS1-5.8S-ITS2 del género Escovopsis.
Palabras clave: Aislamiento, Hongo biocontrolador, Identificación, Secuencias de ADNr.
Abstract: Escovopsis is a genus recently described for which 5 new species have described in the last 6 years. The identification of fungal species is based on morphological structures. Currently, the use of genetic markers based on ribosomal DNA (rDNA) sequences has gained acceptance in numerous applications, such as the molecular identification of the fungal diversity. The objective of this work was to isolate and identify morphologically and molecularly Escovopsis strains native from Argentina. Three strains of Escovopsis were isolated from different samples of soil and fungal gardens from nests of leaf-cutting ants. Taxonomic identification and subsequent DNA extraction was carried out. The ITS1-5.8S-ITS2 region of the rDNA was amplified. This is the first work that records the isolation and morphological identification of strains of fungi of the genus Escovopsis native of Misiones (Argentina): 2 belonging to E. weberi and 1 to E. microspora. Particularly, for the E. microspora strain, it was possible to complement the morphological identification with molecular methods and phylogenetic analysis. The nucleotide sequence obtained from E. microspora represents a contribution for future studies in the area of molecular analysis of the ITS1-5.8S-ITS2 region of the genus Escovopsis.
Keywords: Isolation, Biological control fungus, Identification, rDNA sequences.
Introducción
Las hormigas cortadoras de hojas de la tribu Attini (géneros Atta y Acromyrmex) mantienen una relación de mutualismo obligado con el hongo Leucoagaricus gongylophorus (Möller) Singer (Fisher et al., 1994; Silva et al., 2006). Este mutualismo significa que esta especie fúngica depende exclusivamente de las hormigas para su propagación clonal dentro de cada colonia, así como para la formación de colonias nuevas (Santos et al., 2004). Leucoagaricus gongylophorus forma en la porción terminal de sus hifas unas estructuras especializadas denominadas gongilidios, los cuales representan la principal fuente alimenticia de las hormigas cortadoras de hojas (Moller et al., 2011; Santos et al., 2004).
Los hongos pertenecientes al género Escovopsis (Muchovej y Della Lucia, 1990) son parásitos específicos de los jardines de hormigas cultivadoras de hongos de la tribu Attini (Chomicki y Renner, 2017; Currie, 2001; Currie et al., 2003; Masiulionis et al., 2015; Mueller et al., 2005). En la naturaleza, este nivel de especificidad es tal, que determinadas especies dentro del género Escovopsis se nutren exclusivamente de los tejidos de L. gongylophorus (Masiulionis et al., 2015; Reynolds y Currie, 2004). En consecuencia, el género Escovopsis se cita como posible agente biocontrolador frente a las hormigas cortadoras de hojas (Currie, 2001b; Speckbacher y Zeilinger., 2018; Travaglini et al., 2018).
La fase anamorfa de Escovopsis (Ascomicota: Hypocreales) fue descrita en el año 1990 por Muchovej y Della Lucia. Las claves taxonómicas para las distintas especies del género Escovopsis se basan principalmente en la forma y disposición de los conidióforos, así como en la forma y tamaño de los conidios (Augustin et al., 2013; Masiulionis et al., 2015). Existen hasta el momento 7 especies comprendidas dentro de este género: E. aspergilloides, E. kreiselii, E. lentecrescens, E. microspora, E. moelleri, E. trichodermoides y E. weberi (Augustin et al., 2013; Masiulionis et al., 2015; Meirelles, Montoya et al., 2015). Si bien Escovopsis podría encontrarse en nidos de numerosas especies de hormigas de la tribu Attini, la mayoría de los reportes y registros de especies de este género se corresponden a nidos de hormigas en Brasil. Según bibliografía disponible para Argentina, solo se ha citado la presencia de Escovopsis sp. o E. weberi, pero aún no se reportó información sobre aislamiento y datos morfológicos y moleculares de especies de este género (Marfetán et al., 2015; Meirelles, Solomon et al., 2015).
Los criterios morfológicos de identificación pueden tornarse difíciles debido a que numerosos hongos son microscópicos o tienen ciclos de vida crípticos (Hibbett et al., 2017); incluso en la identificación taxonómica fiable de una especie, también pueden influir la variabilidad morfológica y la necesidad de personal especializado (Leaw et al., 2006). Debido a ésto, se suele recurrir al empleo de técnicas moleculares para identificar y complementar los estudios morfológicos. Los métodos moleculares han sido desarrollados como herramientas adicionales para proveer una identificación más rápida y completa de hongos en comparación con los métodos fenotípicos tradicionales (Barbosa et al., 2018; Hibbett et al., 2017; Leaw et al., 2006). Los diagnósticos basados en ADN proveen atractivas soluciones a los problemas asociados con los métodos tradicionales de identificación de organismos, ya que son independientes de los productos expresados del genoma, así como de la influencia del ambiente (Jaramillo-Pineda et al., 2015).
El objetivo de este estudio fue proporcionar nuevos registros de cepas del género Escovopsis procedentes de nidos de hormigas cortadoras de hojas de Argentina mediante el aislamiento e identificación morfológica y molecular.
Materiales y métodos
Con la finalidad de aislar cepas fúngicas del género Escovopsis, se tomaron muestras de cultivos de hongos y suelo provenientes de 15 nidos de hormigas cortadoras de hojas de los géneros Acromyrmex y Atta. Las muestras se recolectaron en diferentes puntos del sur de la provincia de Misiones (Argentina) y se depositaron en placas de Petri estériles para su traslado al laboratorio.
Pequeños fragmentos de las muestras de aproximadamente 5 mm3 fueron inoculados mediante siembra directa en placas de Petri conteniendo medio de cultivo agar papa dextrosa PDA 39 g/L (p/v - Britanialab), suplementado con el antibiótico cloranfenicol 0.5 g/L. Las placas inoculadas se incubaron durante 5 a 10 días a 28 ± 1 °C.
La identificación morfológica, tanto macroscópica como microscópica hasta las categorías de género y especie, se realizó utilizando las claves taxonómicas y la bibliografía complementaria disponibles en el laboratorio (Augustin et al., 2013; Meirelles, Montoya et al., 2015; Seifert et al., 1995; Spielmann y Putzke, 1998; Wright y Albertó, 2006). Para la identificación microscópica se utilizó un microscopio óptico Carl Zeiss empleando las técnicas de microcultivo y montajes en glicerol 50% (v/v - Biopack) en agua destilada y en lactofenol con azul de algodón. El método de la cinta adhesiva se utilizó para facilitar la observación de características como: tipo y tamaño de conidióforo, forma y disposición de las conidias, pigmentación, entre otras (Prats, 2007; Samson et al., 1988). Para determinar las mediciones microscópicas de las estructuras reproductivas, se calcularon e indicaron los valores medios y desvío estándar de al menos 10 estructuras medidas.
Para la identificación molecular, se cortaron discos cubiertos de micelio joven de las cepas, se colocaron en medio líquido extracto de malta 12.7 g/L (p/v - Britanialab) y se incubaron durante 5 a 7 días a 28 ± 1 ºC para obtener suficiente biomasa. Concluido este periodo, se extrajo ADN a partir de micelio fúngico siguiendo la metodología comentada en Bich et al. (2017) y Castrillo et al. (2012). El ADN genómico extraído se conservó a -20 ºC, hasta el momento de su utilización. La región ITS fue amplificada, secuenciada y contrastada con las bases de datos moleculares (Castrillo et al., 2012; Schoch et al., 2012; Taylor et al., 2000). Se utilizaron los cebadores universales ITS1 e ITS4 para la amplificación de la región ITS1-5.8S-ITS2, debido a que la misma está indicada como código de barras genético principal para hongos y posee el mayor número de secuencias disponibles en las bases de datos (Brown et al., 2014; Hibbett et al., 2017; Schoch et al., 2012; White et al., 1990).
Se preparó una reacción maestra de PCR a volumen final de 20 μL conteniendo agua libre de DNAsa, Buffer 1X, MgCl2 2.5 mM, dNTPs 200 μM, 10 pmol de cada uno de los cebadores universales y Taq polimerasa 0.5 unidades (InBio, Argentina). Se utilizó un termociclador Hangzhou Bioer Technology CO (GenePro Thermal Cycler modelo TC-E-48D, B-48D). El programa de ciclado utilizado consistió en una desnaturalización inicial a 94 °C durante 4 min, seguida de 35 ciclos de 40 s a 94 °C, 40 s a 51 °C y 40 s a 72 °C. Finalmente, se realizó una extensión final a 72 °C durante 10 min.
Los resultados de los productos de amplificación por PCR se verificaron en geles de agarosa al 2% (p/v) a 110 V por 30 min (Sambrook et al., 1989). Para la visualización de las bandas, los geles se tiñeron con solución de Gel Red (Biotium). La secuenciación de los productos de amplificación se realizó por el servicio de secuenciación automática de MACROGEN, Korea. Dichas secuencias se analizaron in-silico mediante herramientas bioinformáticas.
Se utilizó el programa Geneious 9.1.5 para la construcción de una secuencia consenso y se realizó un análisis de identidad y similitud mediante la herramienta Blast contra la base datos de nucleótidos del NCBI (Altschul et al., 1990; Raja et al., 2017).
Para el análisis filogenético de las secuencias obtenidas, se recuperaron de bases de datos moleculares las secuencias caracterizadas y publicadas del género Escovopsis (Augustin et al., 2013; Masiulionis et al., 2015; Meirelles et al., 2015a) y se realizó el análisis por los métodos estadísticos del vecino más cercano (NJ, por sus siglas en inglés), máxima parsimonia (MP) y máxima similitud (ML) (Nei y Kumar, 2000), utilizando la prueba de bootstrap con 1,000 replicaciones. Se utilizó el modelo de Tamura-Nei para el cálculo de la distancia genética. La secuencia ITS1-5.8S-ITS2 del organismo Glomerella cingulata (FJ904831) fue utilizada como grupo externo para el enraizamiento de los árboles.
Resultados
A partir del muestreo realizado en cultivos de hongos y suelo asociado a nidos de hormigas cortadoras de hojas pertenecientes a la tribu Attini, géneros Acromyrmex y Atta, fue posible obtener 3 cepas pertenecientes al género Escovopsis. Estas cepas fueron codificadas como HEP15, HEP18 y HEP25 e ingresadas para su preservación al cepario de hongos de interés biotecnológico del Instituto de Biotecnología Misiones (InBioMis - Universidad Nacional de Misiones) bajo los números de acceso LBM 214, LBM 215 y LBM 209, respectivamente.
Escovopsis microspora Evans y Augustin, 2013 (Augustin et al., 2013)
GenBank: KX816865
Características morfológicas. La cepa HEP25 presentó crecimiento in vitro relativamente lento, cubriendo el 60% de la placa de Petri con PDA a los 7 días de incubación a 28 ± 1 ºC. Sus colonias presentaron forma circular con bordes regulares lisos, con la presencia de micelio aéreo y de aspecto pulverulento de coloración blanca que luego adquirió una tonalidad marrón solo en el centro (Fig. 1A). En la observación microscópica, la cepa fúngica presentó hifas septadas, esporangióforos hialinos de aspecto vesicular (característica típica de la mayoría de las especies del género Escovopsis) de 9.7 ± 1.2 μm de diámetro, y fiálides hialinas de estructura ahusada de 1.8 ± 0.5 μm de diámetro. Esta cepa presentó conidias globosas a subglobosas de 2.3-2.8 μm de diámetro, de paredes delgadas, dispuestas en cortas cadenas rectas, inicialmente hialinas adquiriendo luego una coloración marrón intensa (Fig. 2A). Todas estas características morfológicas permitieron identificarla como correspondiente a la especie E. microspora.
Figura 1
Imágenes fotográficas macroscópicas del anverso de las cepas fúngicas obtenidas luego de 7 días de crecimiento. A) HEP25; B) HEP15; C) HEP28.

Figura 2
Imágenes fotográficas microscópicas correspondientes a las cepas fúngicas. A) HEP 25; B) HEP15; C) HEP18. Barra 20 µm. Las flechas indican los conidióforos. Tinción con lactofenol adicionado con azul de algodón.
Resumen taxonómico
Hábitat. Asociado a cultivos de hongos de nidos de hormigas cortadoras del género Acromyrmex, muestreado en febrero/2014.
Material estudiado. HEP 25: Argentina. Capioví (Departamento Libertador General San Martín) - Misiones (26°55’26” S, 55°03’39” O).
Comentarios taxonómicos
La principal diferencia que presenta esta especie con respecto a las demás especies del género Escovopsis es el pequeño tamaño de sus conidias (< 3 µm). Según lo reportado por Augustin et al. (2013), ésta es la principal característica morfológica que diferencia a E. microspora de las especies E. weberi (con conidias de 3-4 µm) y de E. moelleri (con conidias > 8 µm), además de las diferencias encontradas de acuerdo a sus secuencias de ADN.
Escovopsis weberiMuchovej y Della Lucia, 1990
Características morfológicas. Las cepas HEP15 y HEP 18 presentaron crecimiento in vitro rápido, cubriendo el 90% de la placa de Petri con PDA a los 7 días de incubación a 28 ± 1 ºC. Sus colonias presentaron forma irregular con bordes irregulares, con abundante micelio aéreo laxo y de aspecto pulverulento, inicialmente de color blanco que luego a partir del tercer día de incubación adquirieron una tonalidad marrón (Fig. 1B, C). En las observaciones microscópicas, las cepas fúngicas presentaron hifas septadas, esporangióforos hialinos de aspecto vesicular de 9.3 ± 0.6 μm de diámetro y fiálides hialinas de estructura ahusada de 2.4 ± 0.15 μm de diámetro. Estas cepas presentaron conidias globosas a subglobosas de 2.7-3.2 μm de diámetro, de paredes delgadas, dispuestas en cortas cadenas rectas, inicialmente hialinas adquiriendo luego una coloración marrón intensa (Fig. 2B, C). Todas estas características morfológicas permitieron identificarlas como correspondientes a la especie E. weberi.
Resumen taxonómico
Hábitat. HEP 15: Asociado a cultivos de hongos de nidos de hormigas cortadoras del género Acromyrmex, muestreado en febrero/2014. HEP 18: asociado a cultivos de hongos de nidos de hormigas cortadoras del género Atta, muestreado en Mayo/2014.
Material estudiado. HEP 15: Argentina. Santo Pipó (Departamento San Ignacio) - Misiones (27°09’49” S, 55°21’59” O). HEP 18: Argentina. Posadas (Departamento Capital) - Misiones (27°25’52” S, 55°53’42” O).
Comentarios taxonómicos
Estas cepas presentaron morfología microscópica y un tamaño promedio de conidias similar al reportado para la especie E. weberi (Augustin et al., 2013; Muchovej y Della Lucia, 1990).
Identificación molecular de las cepas de Escovopsis
Fue posible extraer ADN genómico a partir del micelio de cada cepa fúngica aislada. Se obtuvieron de 155 a 274 μg/mL de ADN genómico de buena calidad (absorbancia 260 nm/280 nm 1.8). El análisis del producto amplificado por PCR en geles de agarosa mostró una banda de aproximadamente 600 pb para cada una de las cepas.
En el análisis de identidad de las secuencias nucleotídicas obtenidas de buena calidad se verificó un índice de identidad de 100% de la cepa HEP25 con E. microspora (NR137594); sin embargo, las secuencias nucleotídicas de las cepas HEP15 y HEP18 no presentaron índices de identidad elevados con secuencias reportadas del género Escovopsis. Particularmente la secuencia nucleotídica de la cepa HEP15 se alineó con secuencias reportadas del género Blastobotrys, mientras que la secuencia nucleotídica de la cepa HEP18 con secuencias de los géneros Papiliotrema y Vishniacozyma (Tabla 1).

Con el fin de corroborar la identificación molecular obtenida mediante el alineamiento de secuencias, se procedió a realizar un análisis filogenético mediante los métodos NJ, ML y MP. Todos los árboles obtenidos resultaron equivalentes en cuanto a la topología. Se obervó que las secuencias analizadas conformaron 4 clados diferentes. Las secuencias de Escovopsis se ubicaron en un mismo grupo monofilético, soportado por un valor de bootstrap de 100% para NJ, 98% para ML y 96% para MP. La secuencia ITS1-5,8S-ITS2 correspondiente al aislamiento HEP25 formó un clado monofilético con la secuencia reportada como referencia de E. microspora (NR137594), con un valor de bootstrap de 90% para NJ, 87% para ML y 37% para MP. En cambio la secuencia obtenida correspondiente al aislamiento HEP15 formó un clado monofilético con la secuencia reportada como referencia de Blastobotrys attinorum (NR153636) y la secuencia correspondiente al aislamiento HEP18 se ubicó en el clado correspondiente al género Vishniacozyma (Fig. 3). El resultado del análisis realizado de las secuencias de los aislamientos HEP15 y HEP18 no se condicen con los obtenidos por los métodos morfológicos.

Figura 3
Árbol filogenético obtenido a partir del análisis de parsimonia realizado con las secuencias ITS1-5.8S-ITS2 del ADNr de los aislamientos en estudio y de las secuencias seleccionadas de la base de datos del género Escovopsis. Los números en las ramas representan el soporte probabilístico por el análisis de 1,000 replicaciones de bootstrap. Los números de acceso se indican después del nombre de cada especie fúngica.
La secuencia nucleotídica obtenida en el presente trabajo para el aislamiento HEP25 correspondiente a la especie E. microspora, fue depositada en el GenBank bajo el número de acceso KX816865.del nombre de cada especie fúngica.
Discusión
La necesidad de contar con nuevas alternativas para el control de las hormigas cortadoras de hojas ha conducido a que diversos grupos de investigación se centren en la búsqueda de agentes biocontroladores. A pesar de que existen pocos registros de Escovopsis en países del continente americano (Meirelles, Montoya et al., 2015), en Centroamérica, Currie (2001a) ha reportado que del 33 al 75% de los hormigueros se encuentran infectados con estos parásitos fúngicos, mientras que para la región sur de Brasil, según Rodrigues et al. (2008), la frecuencia disminuye a un 22%. Sin embargo, hasta el momento no existen datos acerca de la frecuencia de infección por Escovopsis en los nidos de hormigas cortadoras de hojas en Argentina (Randon, 2015).
En el presente trabajo fue posible obtener 3 aislamientos fúngicos del género Escovopsis a partir de las 15 colonias de hormigas cortadoras de hojas evaluadas.
Los estudios relacionados a la descripción formal de este género son aun escasos (Meirelles, Montoya et al., 2015). La pertenencia de las cepas en estudio al género Escovopsis ha sido determinada principalmente con base en la descripción morfológica realizada por Augustin et al. (2013) y Muchovej y Della Lucía (1990). Sin embargo, las claves taxonómicas basadas en estimaciones de la velocidad de crecimiento propuestas por Augustin (2011) no fueron consideradas por el hecho de que distintas cepas de la misma especie pueden exhibir diferencias con respecto a esta característica. Por ejemplo, la velocidad de crecimiento de distintos aislamientos pertenecientes a la especie E. weberi fue considerada como lenta por Muchovej y Della Lucía (1990) y como rápida por Seifert et al. (1995).
En el presente trabajo se logró la identificación morfológica de 3 cepas del hongo biocontrolador del género Escovopsis. Utilizando las claves taxonómicas establecidas por Augustin et al. (2013), basadas principalmente en el tamaño de los conidios, fue posible estimar la pertenencia del aislamiento HEP 25 a la especie E. microspora y de los aislamientos HEP15 y HEP18 a la especie E. weberi.
A pesar de que se recomienda complementar la identificación morfológica con datos moleculares (Chakraborty et al., 2011), en la base de datos molecular Genbank del NCBI, solo 13 de las 86 secuencias registradas de las regiones ITS de hongos del género Escovopsis están asignadas a una especie determinada. En consecuencia, la gran mayoría de esas secuencias solo fueron registradas como pertenecientes a Escovopsis sp. Por lo tanto, el aislamiento de cepas de hongos del género Escovopsis y posterior identificación y secuenciación de regiones nucleotídicas indicadas como código de barras genético para su posterior registro en bases de datos moleculares constituyen estrategias esenciales para el desarrollo de herramientas complementarias de identificación molecular de estos microorganismos.
En el presente trabajo, mediante la caracterización molecular de las cepas fúngicas se observó que la secuencia del aislamiento HEP25 presentó un índice de identidad de 100% y formó un clado monofilético con la secuencia de referencia de la especie E. microspora (NR137594). En consecuencia, la secuencia nucleotídica correspondiente al aislamiento HEP25 fue depositada en la base de datos, representando una contribución para futuros estudios relacionados al análisis molecular de las regiones ITS15.8S-ITS2 de este género fúngico en Argentina.
Sin embargo, la secuencia del aislamiento HEP15 se alineó con secuencias reportadas del género Blastobotrys y formó un clado monofilético con la secuencia de referencia de la especie B. attinorum (NR153636), y la secuencia del aislamiento HEP18 se alineó con secuencias reportadas de los géneros Papiliotrema y Vishniacozyma y se posicionó en el clado correspondiente al género Vishniacozyma. Estos resultados indican que la información molecular propuesta por las secuencias obtenidas de los aislamientos HEP15 y HEP18, no condice con los resultados obtenidos por los métodos morfológicos. Lo cual puede ser debido a la existencia de un cocultivo en el momento de realizar el proceso de extracción de ADN genómico entre el aislamiento de E. weberi HEP15 con la levadura B. attinorum, y entre el aislamiento E. weberi HEP18 con una levadura del género Vishniacozyma. Carreiro et al. (2004), Lovato-Arcuri et al. (2014) y Masiulionis y Pagnocca (2017) han reportado la presencia de microorganismos adicionales en los cultivos de hongos de los nidos de hormigas de la tribu Attini, tales como hongos filamentosos, bacterias y levaduras de los géneros Blastobotrys, Cutaneotrichosporon, Haglerozyma, Wickerhamomyces y Starmerella. Por tal motivo, se puede suponer que biológicamente estos microorganismos se encuentren íntimamente asociados con hongos como Escovopsis en el microambiente de los cultivos fúngicos de las hormigas de la tribu Attini. Se proponen como perspectivas del presente trabajo realizar la siembra de estos cocultivos para lograr separarlos y realizar la extracción de ADN, amplificación por PCR y secuenciación de la región ITS1-5.8S-ITS2 correspondiente a los aislamientos de E. weberi HEP15 y HEP18 para reportar las secuencias nucleotídicas.
A partir de muestras de nidos de hormigas cortadoras de hojas en la provincia de Misiones (Argentina), ha sido posible aislar de manera exitosa 3 cepas de hongos pertenecientes al género Escovopsis. Este es el primer trabajo sobre el aislamiento e identificación morfológica y molecular de cepas de Escovopsis en el norte de Argentina.
Mediante la caracterización morfológica se determinó que las cepas HEP15 y HEP18 pertenecen a la especie E. weberi, y la cepa HEP25 pertenece a la especie E. microspora. Los métodos moleculares de ADN constituyen herramientas útiles y precisas para el diagnóstico e identificación de hongos biocontroladores del género Escovopsis. Este estudio aporta una herramienta precisa y fácil para complementar la identificación morfológica de hongos del género Escovopsis.
Agradecimientos
Este trabajo se ha realizado con ayuda parcial de la Universidad Nacional de Misiones (16Q524 años 2013-2015). Castrillo y Bich poseen una beca posdoctoral del Consejo Nacional de Investigaciones Científicas y Técnicas de Argentina.
Referencias
Altschul, S. F., Gish, W., Miller, W., Myers, E. W. y Lipman, D. J. (1990). Basic local alignment search tool. Journal of Molecular Biology, 215, 403-410. https://doi.org/10.1016/S0022-2836(05)80360-2
Augustin, J. O. (2011). Novas espécies de Escovopsis, sua dispersão e virulência na simbiose formigas AttiniLeucoagaricus gongylophorus (Tesisdoctoral). Pró-Reitoria de Pesquisa e Pós-Graduação. Universidade Federal de Viçosa. Minas Gerais, Brasil.
Augustin, J. O., Groenewald, J. Z., Nascimento, R. J., Mizubuti, E. S. G., Barreto, R. W., Elliot, S. L. et al. (2013). Yet more ‘‘weeds’’ in the garden: fungal novelties from nests of leafcutting ants. Plos One, 12, 1-17. https://doi.org/10.1371/ journal.pone.0082265
Barbosa, M. S., Barbosa, S. N., Nagamoto, N. S. y Forti, L. C. (2018). Lack of correlation between micro fungi species and chemical control method of Atta treated with toxic baits. Ciência Rural, 48, 1-6. https://doi.org/10.1590/0103-8478cr20170353
Bich, G. A., Castrillo, M. L., Villalba, L. L. y Zapata, P. D. (2017). Isolation of the symbiotic fungus of Acromyrmex pubescens and phylogeny of Leucoagaricus gongylophorus from leaf-cutting ants. Saudi Journal of Biological Sciences, 24, 851-856. https://doi.org/10.1016/j.sjbs.2016.05.010
Brown, S. P., Rigdon-Huss, A. R. y Jumpponen, A. (2014). Analyses of ITS and LSU gene regions provide congruent results on fungal community responses. Fungal Ecology, 9, 65-68. https://doi.org/10.1016/j.funeco.2014.02.002
Carreiro, S. C., Pagnocca, F. C., Bacci Jr, M., Lachance, M. A., Bueno, O. C., Hebling, M. J. A. et al. (2004). Sympodiomyces attinorum sp. nov., a yeast species associated with nests of the leaf-cutting ant Atta sexdens. International Journal of Systematic and Evolutionary Microbiology, 54, 1891-1894. https://doi.org/10.1099/ijs.0.63200-0
Castrillo, M. L, Fonseca, M. I., Bich, G. A., Jerke, G., Horianski, M. A. y Zapata, P. D. (2012). Taxonomy and phylogenetic analysis of Aspergillus section nigri isolated from yerba mate in Misiones (Argentina). Journal of Basic and Applied Genetics, 23, 19-27.
Chakraborty, B. N., Chakraborty, U., Dey, P. L. y Rain, K. (2011). rDNA sequence and phylogenetics analysis of Macrophomina phaseolina, root rot pathogen of Citrus reticulata (Blanco). Global Journal of Molecular Sciences, 6, 26-34.
Chomicki, G. y Renner, S. S. (2017). The interactions of ants with their biotic environment. Proceedings of the Royal Society B: Biological Sciences, 284, 20170013. https://doi.org/10.1098/rspb.2017.0013
Currie, C. R. (2001a). A community of ants, fungi and bacteria: a multilateral approach to studying symbiosis. Annual Review of Microbiology, 55, 357-380. https://doi.org/10.1146/annurev.micro.55.1.357
Currie, C. R. (2001b). Prevalence and impact of a virulent parasite on a tripartite mutualism. Oecologia, 128, 99-106. https://doi.org/10.1007/s004420100630
Currie, C. R., Wong, B., Stuart, A. E., Schultz, T. R. y Rehner, S. (2003). Ancient tripartite coevolution in the attine antmicrobe symbiosis. Science, 299, 386-388. https://doi.org/10.1126/science.1078155
Fisher, P. J., Stradling, D. J. y Pegler, D. N. (1994). Leucoagaricus basidiomata from a live nest of the leaf-cutting ant Atta cephalotes. Mycological Research, 98, 884-888.
Hibbett, D., Abarenkov, K., Kõljalg, U., Öpik, M., Chai, B., Cole, J. et al. (2017). Sequence-based classification and identification of Fungi. Mycologia, 108, 1049-1068.
Jaramillo-Pineda, J., Guerrero-Olazarán, M., Fuentes-Garibay, J. A., Viader-Salvadó, J. M., Meza-García, J. L. y Morales-Ramos, L. H. (2015). Identificación de especies de Meloidogyne utilizando la secuenciación de regiones espaciadoras transcritas internas de ADN ribosomal de estadios juveniles. Revista Mexicana de Fitopatología, 33, 1-11.
Leaw, S. N., Chang, H. C., Sun, H. F., Barton, R., Bouchara, J. P. y Chang, T. C. (2006). Identification of medically important yeast species by sequence analysis of the internal transcribed spacer regions. Journal of Clinical Microbiology, 44, 693-699. https://doi.org/10.1128/JCM.44.3.693-699.2006
Lovato-Arcuri, S. L., Pagnocca, F. C., da Paixão-Melo, W. G., Nagamoto, N. S., Komura, D. L. y Rodrigues, A. (2014). Yeasts found on an ephemeral reproductive caste of the leaf-cutting ant Atta sexdens rubropilosa. Antonie Van Leeuwenhoek, 106, 475-487. https://doi.org/10.1007/ s10482-014-0216-2
Marfetán, J. A., Romero, A. I. y Folgarait, P. J. (2015). Pathogenic interaction between Escovopsis weberi and Leucoagaricus sp.: mechanisms involved and virulence levels. Fungal Ecology , 17, 52-61.
Masiulionis, V. E., Cabello, M. N., Seifert, K. A., Rodrigues, A. y Pagnocca, F. C. (2015). Escovopsis trichodermoides sp. nov., isolated from a nest of the lower attine ant Mycocepurus goeldii. Antonie Van Leeuwenhoek , 107, 731-740. https://doi.org/10.1007/s10482-014-0367-1
Masiulionis, V. E. y Pagnocca, F. C. (2017). Rhodosporidiobolus geoffroeae sp. nov., a basidiomycetous yeast isolated from the waste deposit of the attine ant Acromyrmex lundii. International Journal of Systematic and Evolutionary Microbiology , 67, 1028-1032. https://doi.org/10.1099/ijsem.0.001738
Meirelles, L. A., Montoya, Q. V., Solomon, S. E. y Rodrigues, A. (2015). New light on the systematics of fungi associated with Attine ant gardens and the description of Escovopsis kreiselii sp. nov. Plos One, 10, e0112067. https://doi.org/10.1371/ journal.pone.0112067
Meirelles, L. A., Solomon, S. E., Bacci, M., Wright, A. M., Mueller, U. G. y Rodrigues, A. (2015). Shared Escovopsis parasites between leaf-cutting and non-leaf-cutting ants in the higher attine fungus-growing ant symbiosis. Royal Society Open Science, 2, 150257. https://doi.org/10.1098/ rsos.150257
Moller, I. E., De Fine-Licht, H. H., Harholt, J. y Boomsma, W. G. (2011). The dynamics of plant cell-wall polysaccharide decomposition in leaf-cutting ant fungus gardens. Plos One, 6, e17506. https://doi.org/10.1371/journal.pone.0017506
Muchovej, J. J. y Della Lucia, T. M. C. (1990). Escovopsis, a new genus from leaf cutting ant nests to replace Phialocladus nomem invalidum. Mycotaxon, 37, 191-195.
Mueller, U. G., Gerardo, N. M., Aanen, D. K., Six, D. L. y Schultz, T. R. (2005).The evolution of agriculture in insects. Annual Review of Ecology, Evolution and Systematics, 36, 563-595. https://doi.org/10.1146/annurev.ecolsys.36.102003.152626
Nei, M. y Kumar, S. (2000). Molecular evolution and phylogenetics. New York: Oxford University Press.
Prats, G. (2007). Microbiología clínica. Buenos Aires: Editorial Médica Panamericana.
Raja, H. A., Miller, A. N., Pearce, C. J. y Oberlies, N. H. (2017). Fungal identification using molecular tools: a primer for the natural products research community. Journal of Natural Products, 80, 756-770. https://doi.org/10.1021/acs.jnatprod.6b01085
Randon, D. N. (2015). Aislamiento, identificación y caracterización de hongos de los géneros Escovopsis y Leucoagaricus nativos de la provincia de Misiones con prospección biotecnológica para el control de las hormigas cortadoras de hojas. (Tesis deLicenciatura en Genética). Facultad de Ciencias Exactas, Químicas y Naturales, Universidad Nacional de Misiones. Misiones, Argentina.
Reynolds, H. T. y Currie, C. R. (2004). Pathogenicity of Escovopsis weberi: the parasite of the attine ant-microbe symbiosis directly consumes the ant-cultivated fungus. Mycologia, 5, 955-959. https://doi.org/10.1080/15572536.2005.11832895
Rodrigues, A., Bacci, M., Mueller, U. G., Ortiz, A. y Pagnocca, F. C. (2008). Microfungal “weeds” in the leafcutter ant symbiosis. Microbial Ecology, 4, 604-614. https://doi.org/10.1007/s00248-008-9380-0
Sambrook, J., Fritschi, E. F. y Maniatis, T. (1989) Molecular cloning: a laboratory manual, New York: Cold Spring Harbor Laboratory Press.
Samson, R. A., Evans, H. C. y Latgé, J. P. (1988) Atlas of entomopathogenic fungi. Berlin: Springer-Verlag.
Santos, A. V., Dillon, R. J., Dillon, V. M., Reynolds, S. E. y Samuels, R. I. (2004). Occurrence of the antibiotic producing bacterium Burkholderia sp. in colonies of the leaf-cutting ant Atta sexdens rubropilosa. Microbiology Letters, 239, 319-323. https://doi.org/10.1016/j.femsle.2004.09.005
Schoch, C. L., Seifert, K. A., Huhndorf, S., Robert, V., Spouge, J. L., Levesque, C. A. et al. (2012). Nuclear ribosomal internal transcribed spacer (ITS) region as a universal DNA barcode marker for fungi. Proceedings of the National Academy of Sciences, 109, 6241-6246. https://doi.org/10.1073/pnas.1117018109
Seifert, K. A., Samson, R. A. y Chapela, I. H. (1995). Escovopsis aspergilloides, a rediscovered hyphomycete from leafcutting ant nests. Mycologia, 87, 407-413.
Silva, A., Rodrigues, A., Bacci, M., Pagnocca, F. C. y Bueno, O. D. C. (2006). Susceptibility of the ant-cultivated fungus Leucoagaricus gongylophorus (Agaricales: Basidiomycota) towards microfungi. Mycopathologia, 162, 115-119. https://doi.org/10.1007/s11046-006-0037-6
Speckbacher, V. y Zeilinger, S. (2018). Secondary metabolites of mycoparasitic fungi. En R. Vijayakumar y S. S. Raja (Eds.), Secondary metabolites-sources and applications (pp. 37-55). India: IntechOpen.
Spielmann, A. A. y Putzke, J. (1998). Leucoagaricus gongylophorus (Agaricales, Basidiomycota) em ninho ativo de formigas Attini (Acromyrmex asperus). Caderno de Pesquisas, Série Botânica, 10, 27-36.
Taylor, J. W., Jacobsen, D. J., Kroken, S., Kasuga, T., Geiser, D. M., Hibbett, D. S. et al. (2000). Phylogenetics, species recognition and species concept in fungi. Fungal Genetic and Biology, 31, 21-32. https://doi.org/10.1006/fgbi.2000.1228
Travaglini, R. V., Vieira, A. S., Arnosti, A., da Silva-Camargo, R., Stefanelli, L. E. P., Forti, L. C. et al. (2018). Leaf-cutter ants and microbial control. En V. D. C. Schields (Ed.), The complex world of ants (pp. 71-84). India: IntechOpen .
White, T. J., Bruns, T. D., Lee, S. B. y Taylor, J. W. (1990). Analysis of phylogenetic relationships by amplification and direct sequencing of ribosomal genes. En M. A. Innis, D. H. Gelfand, J. J. Sninsky y T. J. White (Eds.), PCR Protocols (pp. 315-322). New York: Academic Press.
Wright, J. y Albertó, E. (2006). Guía de hongos de la región pampeana. II. Hongos sin laminillas. Buenos Aires: Editorial L.O.L.A.
Notas de autor
*Autor para correspondencia: gustavobich@gmail.com (G.A. Bich)